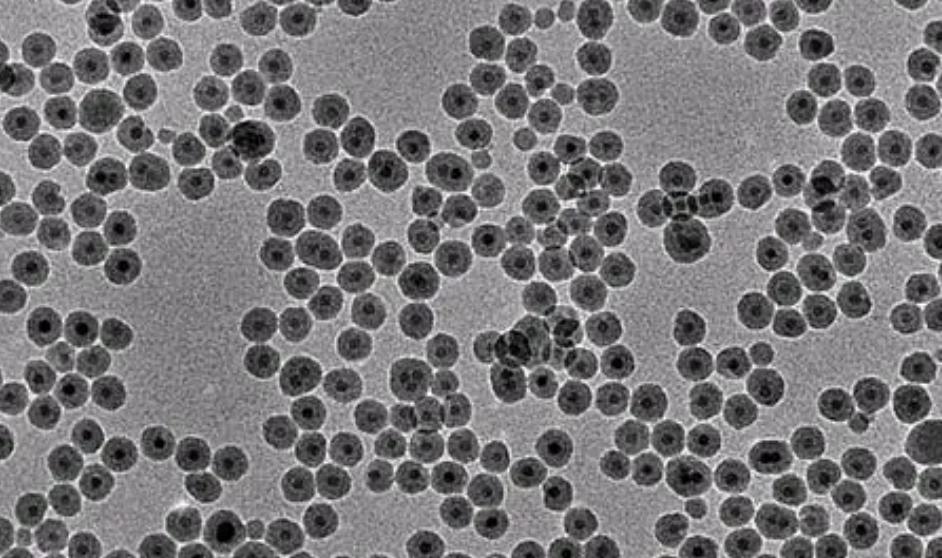
涂料在空间中的应用,纳米涂料的施工方法

文/墨茶
编辑/墨茶
概述
纳米技术 是20世纪80年代后期才刚刚出现的一项新技术,它的主要目标是在0.1一100nm的尺度上,对由物质构成的体系中的电子、原子和分子的运动规律与交互进行研究。

其 研究的目标是按照人的意愿,直接操纵电子、原子或分子,开发出人们所希望的、具有特定功能性质的材料和物品。
纳米技术是一门具有高度交叉的综合性学科,其具体内容有:纳米体系物理学、纳米化学、纳米材料学、纳米生物学、纳米电子学、纳米加工学、纳米力学、纳米机械学。
目前, 在建材,光学,医学,半导体,信息通信,军事等方面已经得到了广泛的应用。
当前,只有利用纳米技术才能达到这个目标。由于具有独特的光学、电学、热学和磁性等特性,使新型建材的开发面临着一场空前的变革。

根据纳米材料的任意角度不同颜色特性研制出的新涂料 ,根据其自清洁特性研制出的抗菌防霉涂料,根据其自清洁特性研制出的PPR给水管,根据其传导特性研制出的导电涂料。
因此,在建筑工程领域, 纳米材料有着非常广泛的市场潜力, 其经济效益和社会效益也是非常巨大的。近几年,国际上对材料领域的研究和开发工作进行了初步探讨,并有了一定的进展。
应用
涂层是建筑的“贴身衣物”和“外层衣物”, 我国现有涂层普遍具有悬浮稳定性差、耐老化、耐洗刷性能差、表面光洁度低等缺点。尽管纳米材料在建筑领域(尤其是建筑涂层)的研究才刚刚起步,但已展现出其独特的优势。

纳米复合涂层指的是将纳米粉末应用于涂层中而获得的一种具有耐老化、抗辐射、高剥离强度或具有特定性能的涂层, 同一颗粒对涂层的影响因颗粒大小而异,而不同类型的颗粒对涂层的影响是一样的。
(1)光学应用纳米复合涂料
由于其尺寸比400-750nm的可见光区要小得多,且对可见光区的光学性质起着渗透效应,因此得到了很高的透光率, 该微球对紫外光有很好的吸附能力。
将纳米颗粒(如二氧化钛、一氧化硅等)加入到建筑外墙涂料中,以改善其抗老化性能;将二氧化钛加入到汽车涂装中,以改善其抗老化性能。
纳米氧化硅,它是一种无定向的白色粉末(指其集聚体),它的表面有不饱和的残键及具有不同键合状态的羟基,其分子状态为立体链状结构。通常情况下, 纳米颗粒上的氢键并不是很强大,很容易被剪裁开来。

但是,当外界的剪切力消失之后,这种氢键又会快速恢复,从而导致材料的结构快速的重构。这个随著时间和外部力量的影响而恢复到原来状态的剪切减弱, 被称作“触变性”。
用纳米二氧化硅制备的普通涂层,其性能提高的一个重要原因就是其触变特性.
徐国财和他的团队采用了一种以纳米颗粒为填料的方法,在UV涂层中加入了纳米二氧化硅。试验结果显示: 添加纳米二氧化硅后,UV光固化涂层对紫外线的吸收率下降,使涂层的硬化速率下降,但对涂层的粘结性和硬度有显著的改善。
尤其是金红石,还可以作为一种效果颜料,当它与其他片状效果颜料,例如:铝粉、珠光等时,将会形成一种伴随着乳光的颜色,可以被用在高档车身表面, 这是当前纳米氧化钛,最大的使用范围,也是在国外将纳米物质在油漆中使用得最好的实例。

由于具有较小的尺寸和较高的比表面积,使得氧化锌在其表界面上呈现出与粒子间的结合状态,使得氧化锌在其表界面上具有较高的催化性能。
本品经紫外线辐射后,具有降解有机物、抑菌、除味等作用。该材料在环境友好型涂层中有着广阔的应用前景。 在涂层中添加了纳米氧化锌后,涂层的抗人为老化性能得到了明显改善。
(2)吸波纳米复合涂料
因其粒径极小,可与电磁波段媲美,故可作为一种新型的吸波材料,对雷达波及红外光均有较高的吸波能力。结果表明, 经该粒子修饰的涂层可以作为*用军**隐形涂层。

美国已成功研制 出一种新型的“超”黑体型纳米吸收剂, 它的雷达波吸收率可达到99%以上,是一种新型的高效率的吸收剂。
可以作为雷达波吸收器使用的纳米粉末包括纳米金属和合金的复合粉末,纳米氧化物粉末,纳米石墨,纳米碳化硅及其混合粉末等。
纳米级的Fe基铁粉、Ni粉和铁氧体粉被国外应用于*用军**隐形涂层,在飞机、舰艇、导弹和潜艇等*器武**上获得了很好的隐身效果。 纳米涂料因其吸收带宽、质量轻、厚度薄等优势,有望成为未来*用军**隐身技术的重要发展方向。
(3)纳米自洁抗菌涂料
光照诱导氧化钛:基体在纳米区内产生具有亲水和亲油两种性质的二元协同纳米界面。这种材料在纳米二氧化钛上会呈现出独特的超双亲性质。

根据此理论,可以对玻璃和建材进行改性,从而达到自洁净、抗雾化的目的。
如果在涂层中使用了在我国已经实现了产业化的纳米抗菌粉末, 就可以制备出纳米杀菌涂层 ,它可以被应用在诸如卫生洁具、室内空间、用具、医院手术间和病房的墙面、地面等建筑材料上,它可以起到杀菌、保洁的作用。
在400nm以下的可见光照射下, 二氧化钛粒子能够在较低的可见光照射下,发生电子跃迁,将价带电子激发至导带,并生成电子-空穴对, 将能量转移至环境中,引发光化学反应,获得光催化活性。

所以它们可以有效地将有机物的降解掉,还可以将油漆表面的污物给降解掉,还可以与细菌中的有机物发生反应,产生二氧化碳和水,这样 就可以实现对细菌的杀死,这可比通常使用的氯气、次氯酸等有更大的效能。
因为二氧化钛在有光的条件下, 具有杀菌、分解有机臭气以及自清洁等功能, 所以,若将二氧化钛制备成纳米颗粒,并加入到涂料中,既可以避免二氧化钛资源的浪费,又可以赋予建筑涂料某种功能,有利于提升其等级,提升其自身的附加值。
纳米氧化锌是一种新型的杀菌材料, 在光照条件下,特别是UV辐射下, 氧化锌 在水中会发生裂解反应,产生带有负电荷的电子,而保留带有正电荷的空穴。

这些孔洞可以将氧气转化成活性氧,并且具有很高的化学反应,可以与各种有机物质(包括微生物内部的有机物质)进行氧化,因此可以 将大部分的细菌和病毒都杀死。
通过对纳米氧化锌的定量分析,发现在5分钟内纳米氧化锌的质量分数为1时,对金葡菌的杀死率为38.86。对大肠埃希菌的杀菌效果达到99.93。因此, 将纳米氧化锌加入到美容产品中,还可以起到遮光、防晒、抑菌、除臭的作用。
(4)纳米防水防火涂料
安徽省五洋纳米涂层制品厂,和中国中科院固态物理所的朝阳,共同研发了一种新型的耐腐蚀涂层。

这种涂层可以有效地解决表面腐蚀、老化、渗漏等问题,其特征在于:涂层中的纳米粒子尺寸较小,能够深入到微观裂缝和多孔结构中,与水泥发生化学反应,生成新型的有机硅化合物, 不但可以使其抗弯强度增加2-3倍,而且还可以发挥防水功能。
由于其极强的粘合性,所以在室温下使用时不会出现任何缝隙,且防水性能特别好;具有很高的延展性,很好的附着力,很好的耐用性; 该产品使用方便,颜色可调节,无毒无污染。
上海湿克威建材公司于2003年,在此基础上,研制出了“漆霸”水基纳米碳氟涂层,并取得了良好的经济效益。

该新一代的氟碳漆,是继美国、日本等公司后,跻身于全球前三名的新型氟碳漆,经过国家油漆品质测试,经过24小时的人工环境老化,在我国属于国际先进的水性油漆,可以为难以施工的高塔、桥梁、高耸的高层建筑物, 提供20年以上的寿命,是一种新型的绿色环保油漆。
北京中国科学院研究中心已成功研制出一种 新型的纳米复合阻燃涂层 ,该涂层采用纳米碳化硅、纳米硅酸盐等与纳米颗粒(如磷酸盐、氧化物和纳米硅酸铝)共混,并与纳米颗粒进行掺杂,形成一种新型的纳米复合阻燃涂层。
2002年,台湾公司开发出一种具 有耐磨性及耐燃性之水基高分子树脂 ,以弥补普通水基树脂之缺点。

真时公司研制开发出的新型水系无机纳米树脂,其 耐热温度超过800摄氏度,并具有自生材料的稳定性、耐磨性和耐燃性。
此产物具有良好的成膜性能和广泛的适用性,与多种材料(特别是水泥)具有良好的粘结性,涂层后不会形成高浓度的密封层,具有良好的透气性。
(5)纳米导电涂料
日本松下公司利用氧化亚铁作为纳米颗粒,开发出了一种新型的防静电性能优良的新型涂层,氧化钛、氧化锌等。
该材料不仅兼具半导体性质,还具备较高的室温导电性和多种色彩, 使其不仅具备良好的静电学性能,还避免了涂层色彩单一的缺点。
(6)纳米高力学性能涂料
作为涂层的主要成分,颜料粒子在涂层中的尺寸越大,其表面的比表面积越大,与涂层之间的粘附力越强,从而 使涂层的硬度、抗冲击及耐磨性能得到显著提升。
同时,通过添加纳米粒子,可以有效地减少涂料在烘干时产生的残余应力,提高涂料的结合力。
前期工作发现,将其添加到UV涂层中,可以显著地改善涂层的表面硬度及粘结力,对家具漆及汽车漆的耐磨及抗擦伤性能也有较大改善。

3应用领域存在的问题与前景展望
此外,在基体中加入纳米物质制成涂层后,其在涂层中的分散性也受到了广泛关注。
如何有效地抑制其在涂层中的再次聚集和发挥其独特的作用,是目前该领域急需突破的技术瓶颈, 在涂层中加入纳米物质时,必须要有适当的用量。
添加量不够,无法达到理想效果;添加量太大,不仅会提高生产费用,而且还会降低漆膜的品质。因而,制备方法的选择对其实际应用至关重要。

纳米粒子具有较高的表面活性 ,其在涂层中的分布是其在涂层中应用的一个重要技术难点。
研究了不同的表面处理方法,不同的添加方式,不同的分散设备,不同的分散设备,对其在涂层中的分散效果有较大的不同。现在的分散方法有三种: 化学分散,物理分散,超声分散。
开发高性能,环境友好,多用途的新型建材,已成为世界各国关注的焦点。目前,国内已经建立了大量的纳米粉体制造公司,但是还没有开拓出在涂料行业中的应用。
而实现纳米材料的优良分散性与功能性,是将其用于建筑涂层中必不可少的一项特殊技术,也一定会对提升建筑涂层等级,促进建筑涂层新的历史性变革起到极大的促进作用。

目前,国际上普遍认为, 纳米科技是关系到未来经济与社会发展的重要前沿科技。
由于其在建材领域的广泛应用,其研发工作才刚开始,因此,它不但能促进新型建材的发展,而且 对人类居住环境和居住品质的提升也将产生巨大的影响。
参考文献
- 纳米材料.北京:化工出版社.
- 纳米材料和技术与发展新型建材.中国建材装备
- 纳米材料和技术在玻璃行业的应用.玻璃
- 纳米科学技术与化学建材.化学建材
- 纳米材料在涂料中的应用.涂料工业
- 纳米复合耐高温防火涂料.电镀与涂饰
- 水性无机纳米级树脂研制成功.化工科技市场